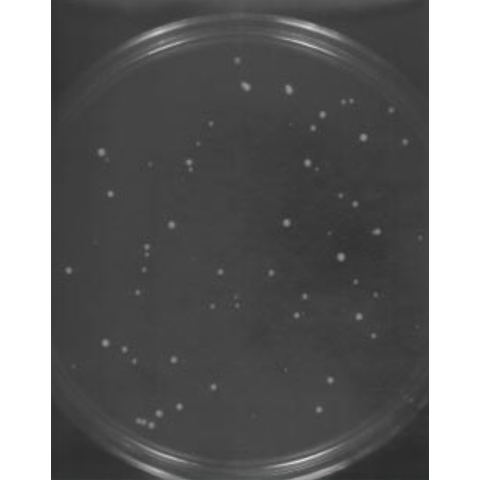
Petri dish with speckled dots, displaying transformed yeast colonies.

Learn how electroporation opens the door to transforming yeast with yeast artificial chromosomes (YACs). In this foundational study, Bell and Mortimer show how the Bio-Rad Gene Pulser™ System with a Pulse Controller can be used to introduce YAC DNA into Saccharomyces cerevisiae. You’ll see how electroporation parameters shape transformation efficiency for both YACs and smaller plasmids, offering practical insight into working with very large DNA molecules in yeast. Read on to see how DNA size and conditions impact transformation outcomes.
Featured Content
Maren Bell and Robert Mortimer, Human Genome Center, Division of Cell and Molecular Biology, Lawrence Berkeley Laboratory, Berkeley, California 94720
Introduction
Transformation of yeast with yeast artificial chromosomes (YACs) has traditionally been performed by a PEG-spheroplast procedure.1,2 However, the procedure is complicated, often unreliable, and transformation efficiencies are relatively low when compared to more recently developed transformation methods. An additional concern is that the smaller YACs of any given ligation mixture are cloned preferentially, therefore prior size fractionation with sucrose gradients to enrich for larger molecules, or treatment with spermidine to improve transformation efficiency of larger molecules, is required to obtain reasonable efficiencies with larger YACs. Several electroporation protocols have recently been reported for the transformation of Saccharomyces cerevisiae with supercoiled plasmids.3-6 In an attempt to improve the currently used YAC cloning procedure, we investigated the electroporation of S. cerevisiae strain AB1380 (Mat a, ade2-1, can1-100, lys2-1, trp1, ura3, his5, psi+) with a 14.4 kb "mini-YAC". Initial experiments showed transformation efficiencies two-fold better than those reported in a previously published YAC electroporation protocol.7
Materials and Methods
The YAC used in our experiments was constructed by the insertion of a 4.6 kb lambda MluI fragment into the MluI-SUP4 cloning site of pYAC-RC.8 E. coli was transformed by the resulting 16.1 kb plasmid, the DNA was isolated, purified over cesium chloride, and restriction digested with BamHI, thereby freeing the telomeres and resulting in a 14.4 kb linear DNA molecule. The restriction-digested DNA was microdialized (Millipore VS, 0.025 µm) against TE (10 mM Tris-HCl, 1 mM EDTA, pH 7.5) for 20 minutes, ethanol precipitated, and suspended in TE. The electroporation protocol used for our experiments was an adaptation of the one devised by Becker and Guarente.5 Exponentially growing cells were harvested by centrifugation, washed twice in water (4 °C), once in 1 M sorbitol (4 °C), and finally resuspended in a 2/3 pellet volume of 1 M sorbitol (4 °C). A 40 µl aliquot of cells was gently mixed with 1-5 µl of DNA (0.1 µg) just before electroporation. A Gene Pulser® apparatus connected to the Pulse Controller accessory was used to pulse the sample in a chilled 0.2 cm cuvette, generating a pulse with a field strength of 7.5 kV/cm (1.5 kV), and a time constant (τ) of approximately 4.2 msec (25 µF and 200 Ω). Ice cold 1 M sorbitol (1 ml) was added immediately after pulse delivery, and 150 µl aliquots were plated on SD ura- plates. Transformants were visible after 3 days of incubation at 30 °C.
Results and Discussion
Transformations with the small YAC have yielded approximately 700 transformants / µg of DNA. Transformations with a supercoiled 5 kb plasmid yielded up to 1.6 x 104 transformants / µg of DNA. A number of parameters were investigated in attempt to increase efficiencies. We found that 0.1 µg of DNA in 1-5 µl of TE or water was the optimum amount for 40 µl of cells (5 x 108 cells). More DNA had an adverse effect on transformation efficiency and less DNA did not seem to saturate the reaction (Figure 3). Spermidine-treated DNA did not yield any transformants. Exponentially growing cells gave the most consistent and highest transformation efficiencies.
A possible problem associated with the high voltage electroporation of very large DNA fragments such as YACs is that the molecules are most likely sheared before they have a chance to enter the cell. Lower voltage experiments with the Gene Pulser apparatus (which generates an exponential decay pulse) have a less disruptive effect on large DNA molecules, but they also yield lower transformation efficiencies.3,4 The use of alternative waveforms may improve on current results.6 The S. cerevisiae strain used here (AB1380) is traditionally employed in PEG-spheroplast transformations and we do not know whether this strain is also a good electroporation candidate. Other strains that have proven to yield high transformation rates might further improve the results presented here.


References
- Burke, D. T., Carle, G. F. and Olson, M. V., Science, 236, 806-812 (1987).
- Burgers, P. M. J. and Percival, K. J., Anal. Biochem., 163, 391-397 (1987).
- Delorme, E., Appl. Environ. Microbiol., 55, 2242-2246 (1989).
- Simon, J. R. and McEntee, K., Biochem. Biophys. Res. Comm., 164, 1157-1164 (1990).
- Becker, D. M. and Guarente, L., Meth. Enzymol., 194, 182-186 (1990).
- Meilhoc, E., Masson, J.-M. and Teissié, J., Bio/Technol., 8, 223-227 (1990).
- Rech, E. L., Dobson, M. J., Davey, M. R. and Mulligan, B. J., Nucl. Acids Res., 18, 1313 (1990).
- Marchuk, D., and Collins, F. S., Nucl. Acids Res., 16, 7743 (1988).
Acknowledgements
This work was supported by Bio-Rad Laboratories and by funds administered through DOE Contract No. DE-ACO3-765F00098 to the Human Genome Center at Lawrence Berkeley Laboratory.
Featured Content
Transfection Solutions

Gene Pulser Xcell Electroporation System
Tried and trusted by thousands of researchers worldwide, transfect every cell type from primary, suspension, and difficult to transfect cells with the Gene Pulser Xcell Electroporation System.

Questions about transfection?

